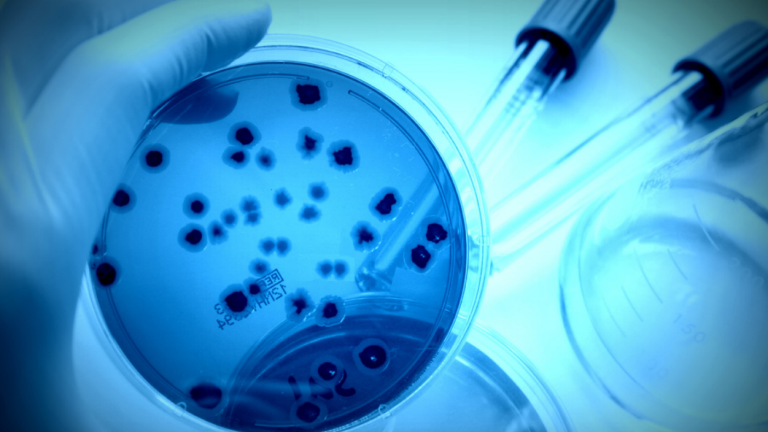

Articole despre HoReCa
Pagina 9
Fiecare spălătorie este diferită, tocmai de aceea Electrolux Professional oferă o gamă largă de mașini de spălat profesionale proiectate și […]
Alegerea celui mai bun grătar profesional pentru bucătăria dvs. poate fi destul de grea, deoarece există atât de multe opțiuni […]
Mașinile de cafea Electrolux Professional sunt concepute pentru a oferi o experiență plină de aromă. Designul și tehnologia sunt combinate […]
Linia de vitrine pentru vin de la Electrolux Professional sunt proiectate să ofere condițiile perfecte pentru vinul dvs indiferent dacă […]
Există mai multe tipuri de întreprinderi mici, ale căror cerințe de curățare depășesc capacitatea echipamentelor electrocasnice și au nevoie de […]
Este un sistem puternic cu circuit închis pentru igienizare și distrugerii virusurilor, precum și pentru îndepărtarea mirosurilor neplacute pentru diverse […]
Rețete preparate folosind tigăile și brasierele basculante de gătit cu presiune Thermaline ProThermic de la Electrolux Professional. Parte a grupului […]
Punctul cheie este intelegerea ca nu tot ce pare curat este si igienizat, iar acest fapt trebuie sa fie pe […]
Uneori, echipamentul dvs. trebuie oprit pentru perioade lungi de timp. Electrolux Professional dorește să vă ofere câteva măsuri care să […]
Indiferent daca este vorba de o bucatarie profesionala sau una casnica, unul dintre lucrurile cele mai importante de luat in […]
Uscatoarele de rufe au fost considerate dintotdeauna cele mai mari consumatoare de energie. Odata cu dezvoltarea industriei de spalatorii au […]
Pentru domeniile care au cerințe de igienă stricte, o mașină de curățat pardoseli aleasă corect devine la fel de valoroasă […]